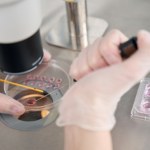
Dolina Krzemowa Zagłębie komputerowe w Kalifornii

Dolina Krzemowa
(Zagłębie komputerowe w Kalifornii)- Wszystkie (7)
- Artykuły (7)
Artykuły (7)
-
Dzieci na zamówienie? Rodzice płacą fortunę za "inteligentne" embriony
- Niedziela, 17 sierpnia 2025 (11:02)
-
Krzemowa Dolina ... Jozafata - wokół książki Kary Swisher "Burn Book"
- Wtorek, 29 kwietnia 2025 (21:15)
Obawiam się takich tematów: dziennikarskiego relacjonowania pracy dziennikarzy. Boję się samozapętlenia, zawodowej ksobności, zamykania się w profesjonalnej bańce. Zawsze pojawia się...Dolina Krzemowa -
Brukselska bazooka celuje w Dolinę Krzemową. UE chce ostro odpowiedzieć Trumpowi
- Środa, 5 lutego 2025 (07:53)